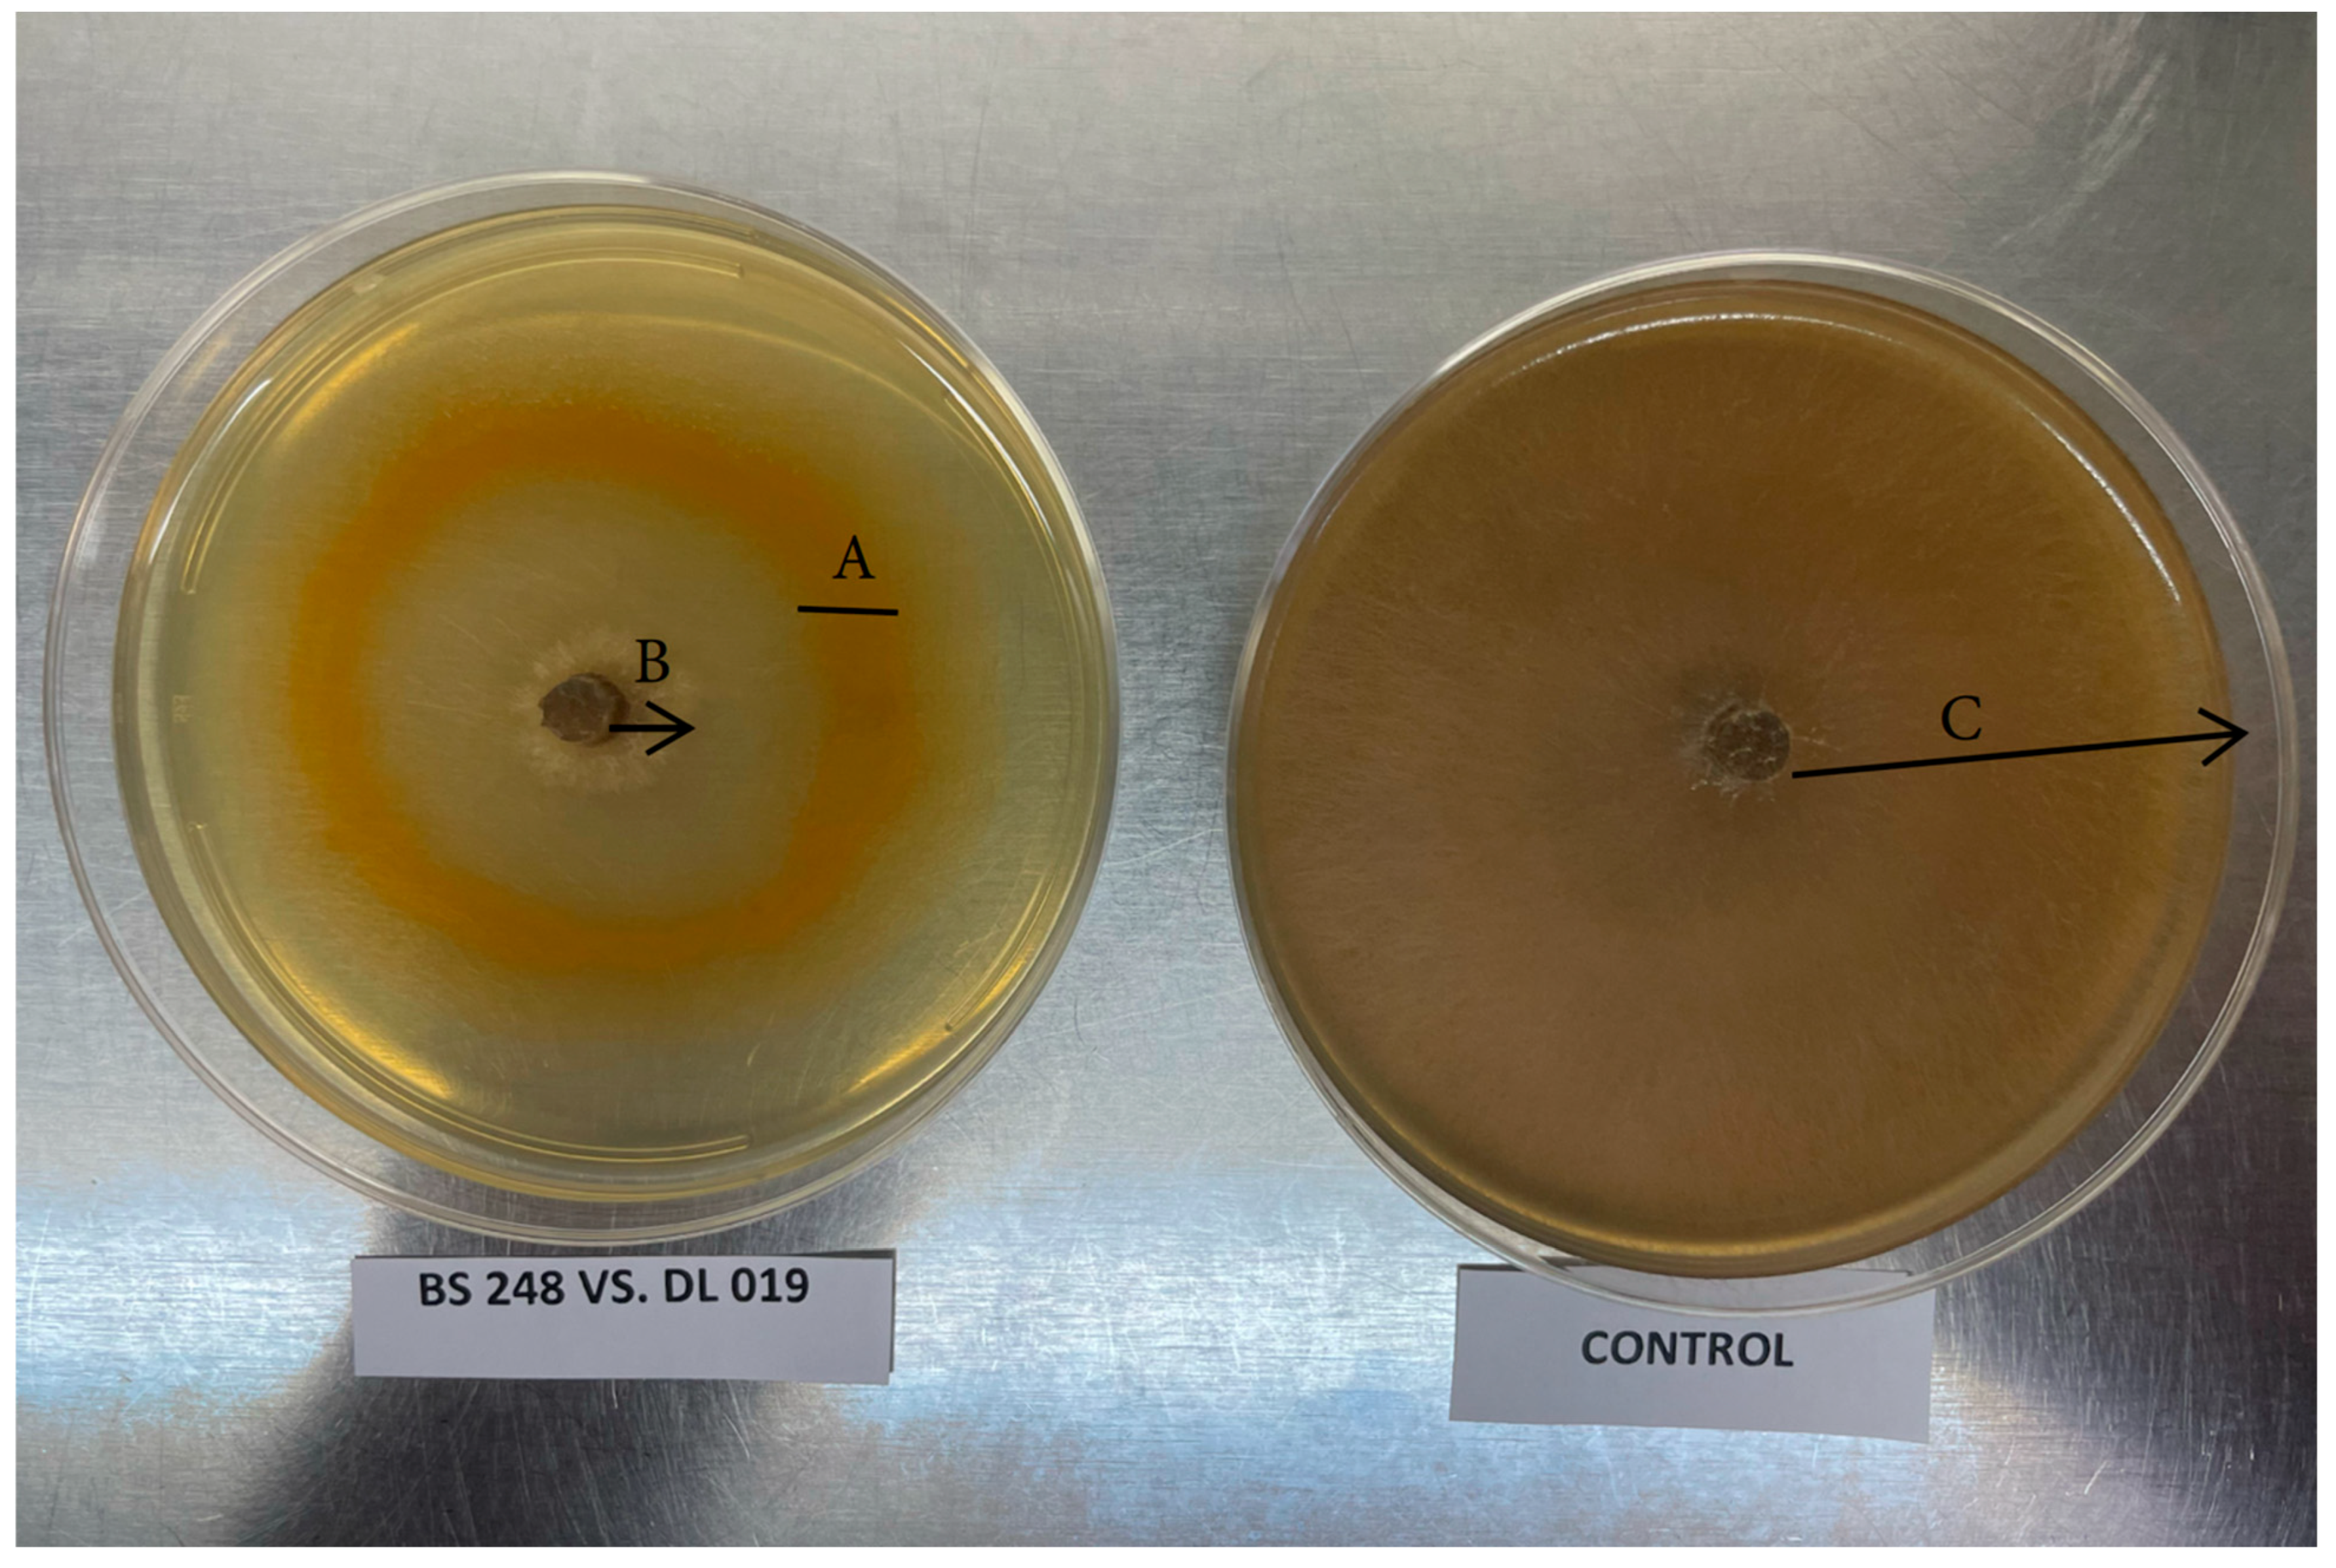
Applmicrobiol 05 00085 g001
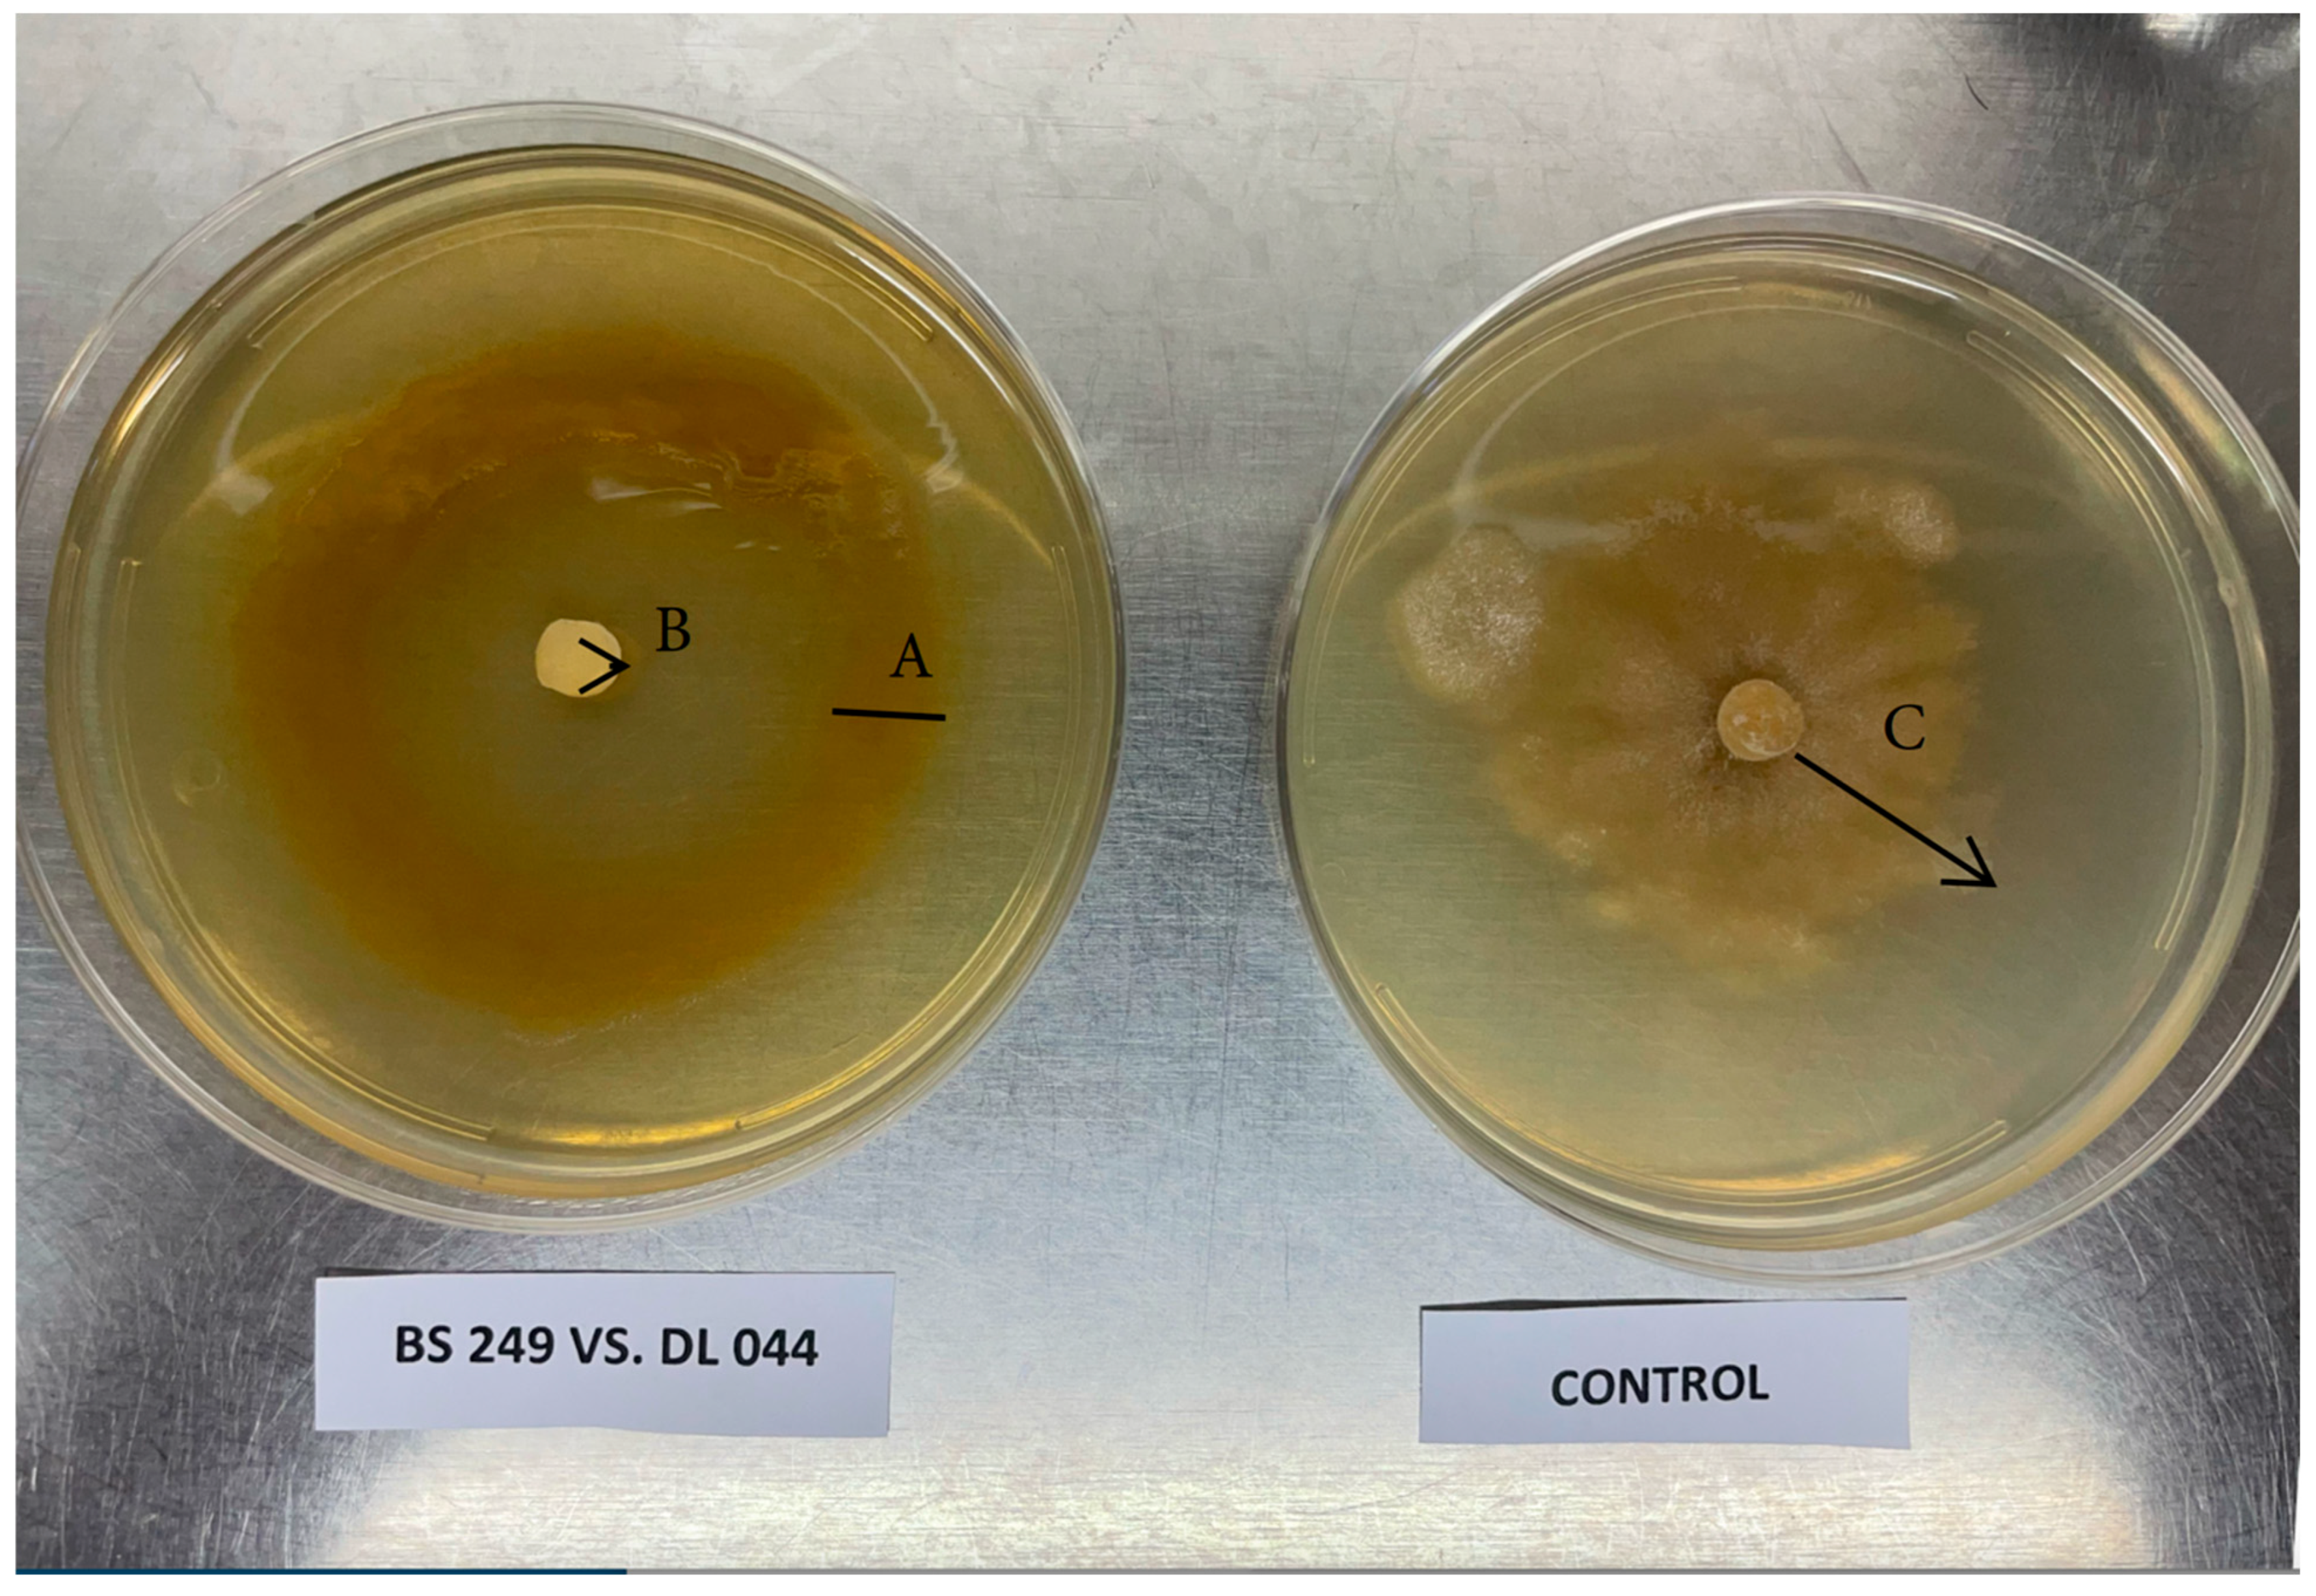
Applmicrobiol 05 00085 g002
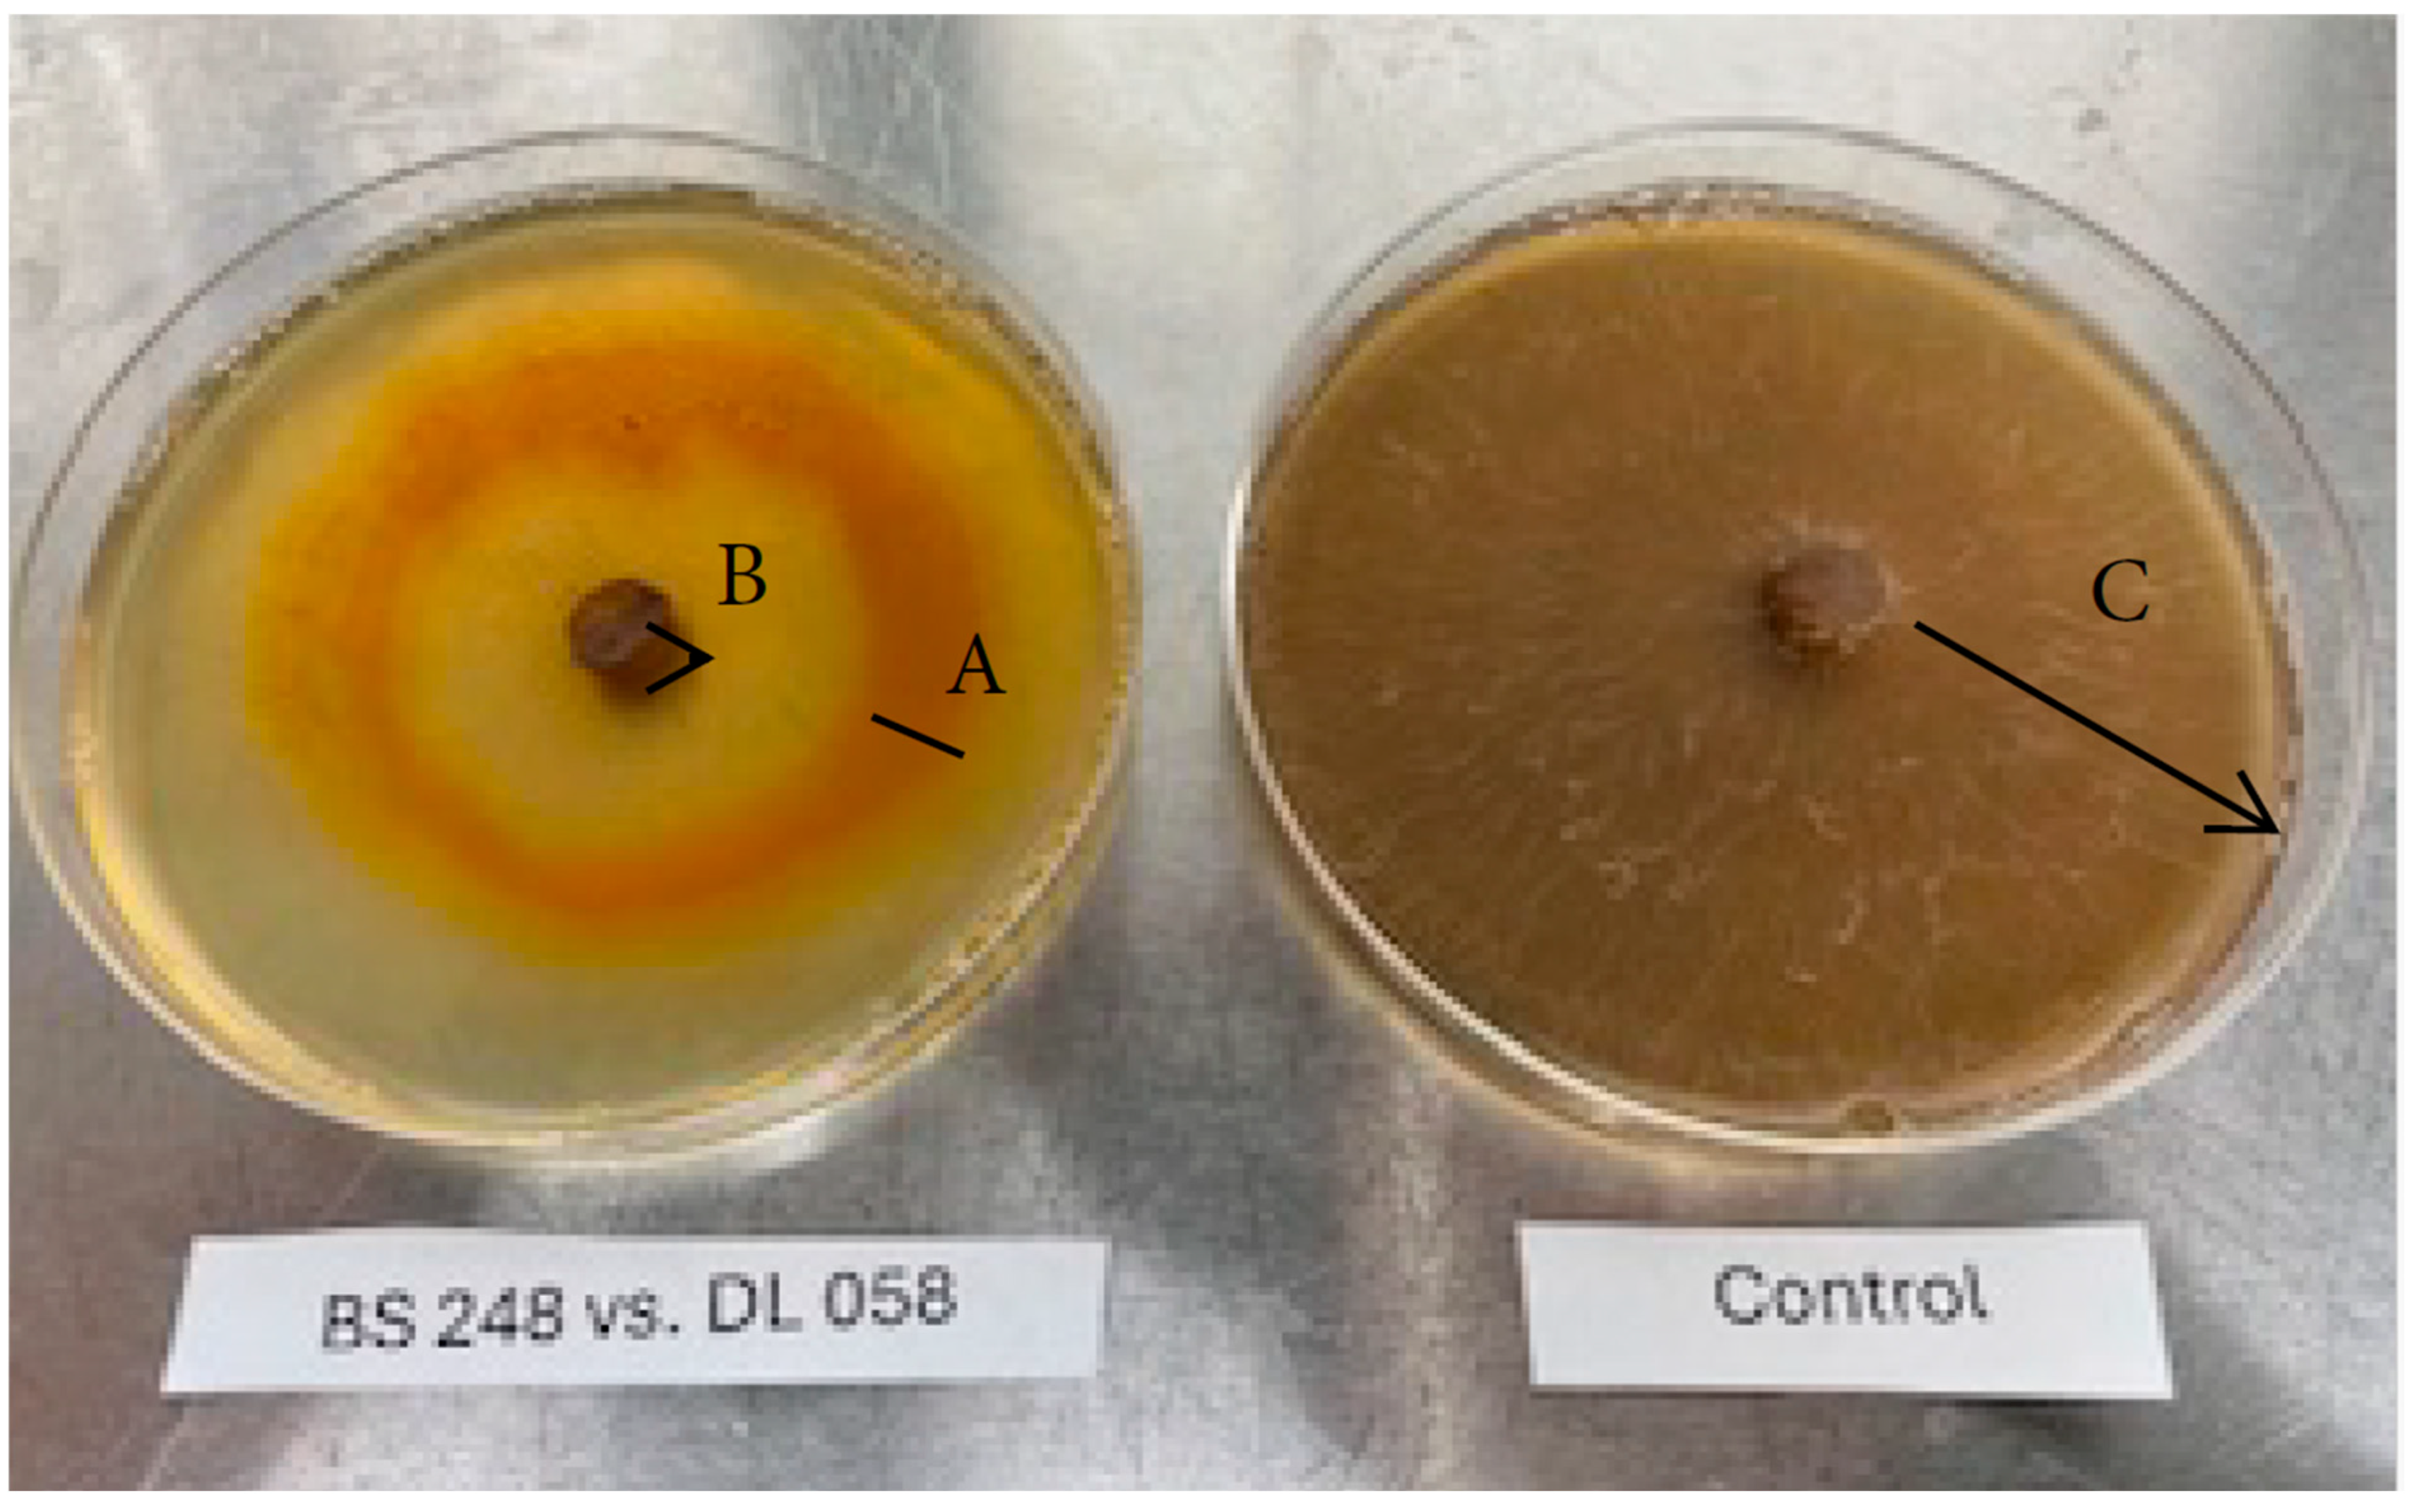
Applmicrobiol 05 00085 g004

1. Introduction
It is estimated that globally 20–30% of the agricultural yield is lost due to diseases, pests, and the ancillary effects of various measures used to control their actions [
1,
2]. Fungal diseases are among the leading causes of crop diseases, representing 70–80% of all such diseases [
3]. The three species of fungi and oomycetes used in this study cause different diseases in different crops.
Rhizoctonia solani is a soilborne pathogen of the division Basidiomycota that causes foliar blight, root rot, seed rot, pre- and post-emergence damping off, and hypocotyl rot in a wide range of hosts, with a worldwide distribution [
4].
Sclerotinia sclerotiorum, also known as white mold, is of the division Ascomycota and can infect over 400 plant species from a wide range of families [
5]. The stem rot caused by
Sclerotinia can lead to devastating economic losses in soybean [
6].
Pythium ultimum, the third pathogen used in this study, belongs to the peronosporalean lineage of oomycetes. It causes damping off and root rot diseases in hundreds of diverse plant hosts, including maize, soybean, potato, wheat, fir, and numerous ornamental species [
7].
While chemical-based fungicides and pesticides are effective at combating plant diseases and, in many instances, necessary, they can have adverse effects on critical natural environmental processes, including soil microbial activities, and increase weed-resistant populations, soil compaction, and water pollution, which seriously affect sustainable agriculture [
3,
8]. Thus, biocontrol using antagonistic microorganisms is seen as an essential alternative strategy for achieving sustainable agriculture within an integrated management program, which includes developing better disease-resistant varieties [
8].
Extensive research aimed at discovering biocontrol agents and the mechanisms underlying their activities has led to the development of a wide range of products that are now marketed and available worldwide. Species of
Trichoderma are among the most widely used microorganisms in such commercial biocontrol products [
9]. Myxobacteria have been known to inhabit soil at concentrations of 10
3–10
5 cells/g of topsoil [
10], and they possess an inherent ability to prey on and kill microorganisms. This group of bacteria are known as producers of secondary metabolites and enzymes that are used to kill and prey on other microorganisms [
11]. The effectiveness of myxobacteria against fungi, bacteria, and oomycetes has been explored previously [
12,
13,
14]. Furthermore, a strain of
Corallococcus was formulated as both liquid and solid preparations, which were effective in both the greenhouse and field against cucumber
Fusarium wilt [
15]. Similarly, a strain of
Myxococcus was found to be an effective biocontrol agent against bacterial soft rot of Calla lily (
Zantedeschia spp.) caused by
Pectobacterium carotovorum [
13]. These investigations clearly demonstrated that
Myxococcus strains have potential use as plant-disease biocontrol agents.
In this study, we examined the inhibitory activity of 13 strains of myxobacteria on four common crop pathogens using modified methods for the challenge study and a new method for the enumeration of myxobacteria. A mixture of two myxobacterial strains was used as an inoculum to control Rhizoctonia solani against cucumber seedlings in pots in growth chambers. The survival of one myxobacterial strain in soil with various ratios of rabbit manure was evaluated. We also discuss the possibility of using these bacteria as biocontrol agents against fungal diseases in support of sustainable agriculture goals and practices.
2. Materials and Methods
2.1. Myxobacterial and Fungal Strains
The myxobacterial strains
Cystobacter fuscus (ATCC 25194),
Myxococcus flavus (ATCC 29617),
M. flavescens (ATCC 51243),
M. virescens (ATCC 29616),
Polyanion brachysporum (ATCC 53080), and
Corallococcus (Myxococcus) coralloides (ATCC 25202) were purchased from the ATCC and propagated according to the supplier’s directions. In addition to the ATCC cultures, the strains
M. xanthus BS 245, BS 248, DK 801, DK 836, and DK 897;
M. stipitatus BS 247; and
M. coralloides BS 249 were available from Dilip Lakshman’s laboratory at the USDA-ARS, Agricultural Research Service, Beltsville, Maryland. These strains were obtained from other collaborators and preserved in 1 mL cryogenic vials in 20% glycerol at −80 °C and are referred to collectively as DL strains. All cultures were grown and maintained on Casitone yeast extract agar (CYEA). The CYEA composition per liter consisted of Casitone (Life Technologies, Detroit, MI, USA) 10 g, yeast extract (Life Technologies Corp., Detroit, MI, USA) 1 g, calcium chloride (St. Louis, MO, USA) 1 g, and agar (Life Technologies Corp., Detroit, MI, USA) 15 g [
16].
The CYEA medium supports good growth for all of the myxobacterial strains and fungal isolates. An incubation temperature of 27.5 °C was chosen, as this is the midpoint for the optimum growth of bacteria (30 °C) and fungal strains (25 °C).
The plant pathogenic isolates used in this investigation were R. solani AG4 (isolate DL 019), R. solani AG2 2LP (DL 058), Sclerotinia sclerotiorum (DL 044), and Pythium ultimum (DL047). Cultures of these four pathogens were grown on Potato Dextrose Agar (PDA, Difco Laboratories, Detroit, MI, USA) for 7 days and used as inoculum. All four of these strains are known to cause various diseases in a range of crops.
2.2. Fungal and Oomycete Growth Rate
The growth rates of all four plant pathogen strains used in this study were determined on Petri dishes (100 × 15 mm) containing 20 mL of CYEA. A 5 mm plug of fungal isolates from actively growing cultures on plates containing PDA was obtained using a sterilized metal cork-borer and placed at the center of the plates with the fungal growth facing the medium. For each strain, five plates were prepared and incubated at 27.5 °C. The radial growth in millimeters was measured four days per week. The average radial growth values with the standard of error for each of the four phytopathogens at various incubation times were calculated using the tool provided at
https://www.allmath.com/standard-error-calculator.php (accessed on 4 August 2025). The data were tabulated.
2.3. In Vitro Inhibition of Pathogens by Myxobacterial Strains
Inhibition of the four fungi and oomycete strains by the myxobacterial strains was measured on CYEA medium (20 mL in 100 × 15 mm Petri dishes). Myxobacteria, actively growing for 3 days, were aseptically scraped from the CYEA media and suspended in 0.5 mL of sterile water and vortexed to achieve a uniform cell suspension for use as inoculum. The latter was spread on the surface of a new CYEA agar plate in the form of a 50 mm diameter ring using a sterile loop. A visual template positioned on the exterior bottom of the Petri dishes served as a guide to position the circular inoculum ring. The plates were handled gently and allowed to absorb the liquid inoculum suspension; thereafter, they were incubated at 27.5 °C. When the bacterial growth ring appeared after 3–5 days, a 0.5 cm diameter plug of the actively growing fungus or oomycete (5 days of growth on PDA) was placed in the center of the ring on the agar’s surface. For each bacterial strain and fungal or oomycete isolate combination, five plates were prepared. Fungal radial growth was measured in mm from the edge of the pathogen plug to the farthest radius of growth after 1, 2, 7, and 14 days. Fungus or oomycete growing on CYEA medium without a myxobacterial ring was considered as the control. A 14-day duration for the trial was selected, because by 14 days the radial growth on the control plates had completely covered the agar surface for most of the pathogens. Also, 14 days is sufficient time for the fungal or oomycete pathogens to grow and cross the bacterial barrier, if they could do so. In each challenge of a pathogen vs. a myxobacterial strain, the radial growth on all five treatment plates and the control plates for each incubation period were averaged and used for calculation of the percent inhibition according to the equation below:
Each pathogen and myxobacterial strain challenge trial was repeated, and the percentage inhibition values of the two trials were averaged, and the results were tabulated.
2.4. Inhibition of Rhizoctonia by Myxobacteria in Pots
Cucumber seedlings were propagated from seeds (Heirloom organic, Purely Organic Marketmore 76, SimplyGro LLC, Manchester, NH, USA) germinated in 1.9 L pots containing Pro-Mix potting soil (Quakertown, PA, USA). Seedlings were 20 days old with four leaves when used.
The Rhizoctonia inoculum used in the experiment was prepared according to the method described as follows: Mycelia from two plates each for R. solani AG 4 DL 019 and R. solani AG2 DL 058 covering the entire surface of the PDA in the Petri dishes (100 × 15 mm) were harvested using sterile scalpels, added to 100 mL of sterile distilled water, and then blended in a sterile standard food-grade blender for 1 min.
Myxobacterial inoculum was prepared by scraping the surface of 5 plates each of strains BS 249 and BS 248 grown separately on CYEA medium for four days. The scraped bacteria were added to 100 mL of sterile distilled water and blended for 1 min, as described above for the Rhizoctonia inoculum preparation.
The experiment began as follows: 2 mL of
Rhizoctonia inoculum prepared as described above was added to containers (volume of about 400 mL) filled with moistened potting soil Pro-Mix (Quakertown, PA, USA). The inoculum was mixed with the soil using a spatula and left overnight in the laboratory for the
Rhizoctonia to initiate growth.
Rhizoctonia was not added to the pots designated as controls. After 24 h, two seedlings, prepared as described above, were transplanted into the containers. After transplanting, an inoculum of myxobacteria was added to the pots to prepare four different treatments, as indicated in
Table 1 below.
For each of the four treatments, two pots with two seedlings each (totaling 4 seedlings per treatment) were prepared and incubated in a growth chamber (Conviron, Controlled Environments Inc., Pembina, ND, USA) set at 27 °C and 50% relative humidity, with a 12 h. alternating light/dark cycle. Seedlings were monitored for growth and signs of disease, and they were watered every other day with 30 mL distilled water. After two weeks, the pots were photographed, the three largest leaves from each treatment were cut, and the dimensions (width and height) were measured in mm. The leaf dimensions were analyzed statistically using ANOVA and the Tukey HSD test, at
p = 0.05, using an online tool available at
https://www.socscistatistics.com/tests/anova/default2.aspx (accessed on 10 June 2025).
2.5. Survival of Myxobacteria Strain BS 248 in Soil Amended with Rabbit Waste
Rabbit manure purchased from HDH Company, St. Louis, MO, USA, was ground in a blender into fine particles and mixed with soil obtained from corn–soybean-rotated fields at the Beltsville Agricultural Research Center (10300 Baltimore Avenue, Beltsville, MD, USA) to obtain concentrations of (w/w) 0, 25, 50, 75, and 100% manure in soil. The soil and rabbit manure mixture (total weight: 10 g) was mixed in flasks and autoclaved for 30 min; autoclaving was repeated twice on consecutive days. Thereafter, the mixture was aseptically transferred to 50 mL sterile Falcon tubes. Sterile deionized water was added to the mixture to moisten but without excess standing liquid. Duplicate tubes were used for each combination of soil and rabbit fecal pellets. Inoculum for the experiment was prepared by scraping biomass, using a sterile inoculation loop, from three days’ growth of M. xanthus BS248 on CYEA medium in a single 100 × 15 mm Petri plate, transferred to 10 mL of sterile saline solution, and vortexed to a uniform suspension, from which 1 mL was added to each tube containing the soil–manure mixture. The bacterial count of the inoculum was determined using serial dilutions of the suspension (10−1–10−6) performed in tubes containing 9 mL of sterile 0.9% saline solution, from which 0.1 mL of the dilutions was distributed on two plates of CYEA medium as 20 drops of 5 µL each, since spreading of inoculum usually appears as a mass of growth without distinction of individual colonies. Similarly, the myxobacterial strain in the soil mixture was measured weekly by aseptically transferring 1 g of the mixture into 9 mL of sterile saline solution for a dilution of 10−1. From the latter, serial dilutions of 10−2–10−5 were prepared, and 0.1 mL from each dilution was added to two plates of CYEA as 20 drops of 5 µL. Plates were incubated at 27.5 °C and checked for two weeks for the presence of typical colonies of myxobacteria. The dilution with the highest number of bacteria/g was recorded.
4. Discussion
Myxobacteria are soil-inhabiting, Gram-negative, and rod-shaped bacteria. Based on their feeding habits, they comprise the following two groups: (a) bacteriolytic, which feed on microorganisms, and (b) cellulolytic, which hydrolyze cellulose and feed on dead cells. The majority of cultured myxobacteria are bacteriolytic, and, thus, the group has biocontrol application potential [
17]. In this investigation, the inhibitory effect of 13 myxobacterial strains belonging to four genera was tested against four strains of three different plant pathogens. Three of the pathogens were fungal species, and one belonged to oomycetes, a distinct phylogenetic lineage of fungus like eukaryotic microorganisms. These species are among the most common crop pathogens and together with a few other common pathogens, such as
Fusarium,
Phytophthora, and
Verticillium, can cause yield losses of up to 75% in cereals, cotton, and horticultural vegetables [
18]. Different inhibition levels were shown by the strains of myxobacteria. Three strains, all belonging to the genus Myxococcus (
M. xanthus BS 248,
M. coralloides BS249, and
M. flavus ATCC 29617), were placed in the high-inhibitory strain category for their high inhibition of all of the phytopathogens. This genus is the most frequently occurring around the world in soil with a pH range of 5–8 [
10]. It is essential to note that within Myxobacteria, the ability to produce certain inhibitory compounds is typically a strain characteristic, rather than a species characteristic. This explains why some of the strains of
M. xanthus were highly inhibitory to the pathogens, whereas others were not [
16].
The growth rate of the pathogens was an essential factor determining the inhibitory effect. In general, the myxobacterial strains were more potent against slow-growing pathogens than against fast-growing ones. All 13 strains of myxobacteria tested were less inhibitory toward
P. ultimum DL 047 than
S. sclerotiorum DL 044; the two pathogens differed in growth rate, with DL 047 exhibiting a higher rate than DL 044. Also, in the 26 challenges between the two high-growth-rate fungi,
R. solani strains DL 019 and DL 058, and the 13 myxobacteria strains, in 8 out of those 26 challenges, the inhibition levels dropped to zero after two weeks of incubation, as the pathogen crossed the bacterial growth line. However, crossing of the bacterial line happened only in 1 case out of the 26 challenges between the two slow-growing pathogens
P. ultimum DL 047 and
S. sclerotiorum DL 044 and the 13 myxobacterial strains. In agreement with this study, it has been reported that species of the genera
Pythium and
Sclerotinia were the most sensitive to the effect of myxobacteria, while the fast-growing fungi such as
Fusarium and
Verticillium were resistant to the myxobacterial inhibitory effects [
12]. It is noteworthy to report that in [
12], the plates in the challenge study were incubated at room temperature, which is not a definitive statement. Therefore, the temperature could have favored either the pathogen or the predatory bacteria. In this study, however, the incubation temperature of 27.5 °C is equally favorable to the pathogens and myxobacteria, as it is the midpoint between the optimum growth temperature of 25 °C and 30 °C for the pathogens and bacteria, respectively.
The results reported here shed light on some aspects of the mode of action of myxobacterial strains on the pathogen species. Against the three fungal species, as shown in
Figure 1,
Figure 2 and
Figure 4, we observed that the inhibition of the fungi did not require any contact with bacterial growth, as there is a clear zone between the fungal plug and the bacterial growth lines. However, against the oomycete species
P. ultimum (
Figure 3) there was no clear zone between the fungal inoculum plug and the bacterial growth. Growth of the pathogen was stopped upon contact with the bacterial growth line. Myxobacteria are known to produce a large number of metabolites with unique structures [
19]. Low-molecular-weight biomolecules will diffuse faster than lytic enzymes in media and will lead to inhibition or lysis of fungal cells without any contact. Myxovirecin, an antibiotic produced by
M. xanthus, was proven responsible for the inhibition of
Escherichia coli based on studies with a mutant of
M. xanthus defective at producing the antibiotic [
20].
Regarding the inhibition upon direct physical contact, it can be explained by the presence of high-molecular-weight, less mobile lytic enzymes that remain near the bacterial line, thereby lysing a pathogen upon direct physical contact. The difference in cell-wall components of fungi and oomycete could reflect the difference in the way the myxobacterial strains exert their inhibition. The main component of fungal cell walls is chitin, whereas cellulose is the predominant component of cell walls of oomycetes. The lytic enzymes β-1,6-gluconase, β-1,3-gluconase, chitinase, protease, and peptidase are the main enzymes that participate in cell predation [
19].
There have been reports of inhibitory effects of volatile compounds produced by myxobacteria. The myxobacterial strain “
Corrallococcus sp. EGB” emits volatile organic compounds (VOCs) that have a significant inhibitory effect on various fungal plant pathogens, demonstrating potential as a biocontrol agent against fungal plant diseases [
21]. However, the cultures we used had no discernible smell or odor and, thus, it is possible that VOCs had no impact on the inhibition rates in these challenge studies.
When tested in pots against
R. solani isolates DL 019 and DL 058, a mixture of two strains,
M. xanthus BS 248 and
M. coralloides BS249, prevented the effect of the pathogens in cucumber. Additionally, the plants in pots amended with myxobacteria were larger and greener with bigger leaves than plants grown in pots not inoculated with
Rhizoctonia and myxobacteria (controls), suggesting possible growth-promoting abilities of some myxobacterial strains. We are unaware of previous reports of growth promotion by myxobacteria. However, some strains of other biocontrol agents like
Trichoderma have been reported as providing growth-promotion activities [
22].
During this study, it was observed that the myxobacterial strains did not survive well on the plates. In general, the cultures on CYEA medium needed to be transferred to new plates within 10 days to maintain the cultures in a viable state. Also, the strains of myxobacteria did not grow well in liquid media. Thus, we emphasize that the viability of myxobacteria will be a critical factor in using these microorganisms in products for amending soil for biocontrol. Another possible way to take advantage of the inhibitory capacity of these bacteria against pathogenic fungi, as well as other types of pathogens, is to manage soil conditions that favor enrichment of these myxobacteria in soil specifically and increase microbial diversity in general. Reduction in soil microbial diversity has been implicated in increased soilborne pathogens [
23]. In an extensive field study, the results showed that the addition of swine manure to the soil increased the abundance and density of myxobacteria in the soil. In contrast, nitrogen fertilizers decreased both the abundance and density of this group of bacteria [
24]. These results agree with the findings of the study reported here, that soil amended with rabbit manure increased the survival of a species of myxobacteria compared to non-amended soil. Our results also show that the myxobacteria did not increase significantly in the soil during incubation, suggesting that myxobacterium
M. xanthus strain BS 248 may prefer to obtain the required nutrients by preying on other microorganisms rather than from media or organic matter in the soil. This could be the reason for the poor growth and survival of these bacteria in typical laboratory media.